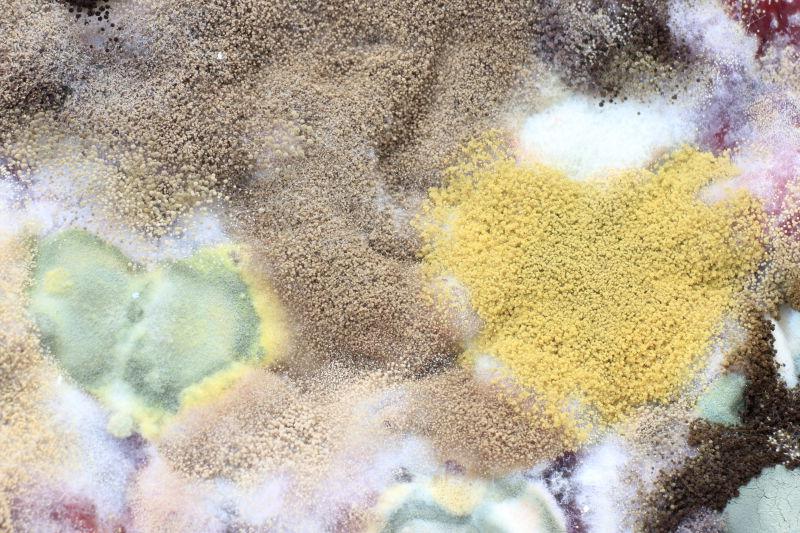
各种颜色的霉菌,霉菌一般有几种颜色

霉菌有各种形状、大小和颜色,虽然有些人可能认为颜色可以作为一种识别特征,但不幸的是,它不是。识别霉菌的主要手段是仔细观察其结构、孢子和生长形态,如果没有进入实验室,这并不容易做到。颜色并不是区分霉菌或毒性的一个很好的特征,因为一个斑块可以有多种颜色,或因多种原因而改变颜色。影响霉菌颜色的一些因素是:食物的种类,湿度水平以及光照条件。
无论霉菌是什么颜色,如果它出现在你的房子里,那就说明有一个活跃的湿气问题,应该尽快清除。以下是你可能在家中发现的霉菌的颜色。
绿色霉菌
绿色是霉菌最常见的颜色。霉菌有数十万种类型,其中数千种在其生命中的某个阶段会出现绿色。因此,当涉及到绿色霉菌时,颜色并不能说明什么,但有可能是这三种霉菌之一:曲霉菌(Aspergillus)、青霉菌(Penicillium)、枝孢菌(Cladosporium)。
黑霉菌
黑霉菌是霉菌家族中臭名昭著的成员,但不是所有的黑霉菌都是有毒。虽然尽快处理所有的霉菌很重要,但处理有毒的黑霉菌应该由专业人士来处理。有几种不同的黑霉菌可以在日常的家中见到,所以注意某些特征可以让你知道清除黑霉菌的紧迫程度。
葡萄穗霉(Stachybotrys)属
纸葡萄穗菌(Stachybotrys chartarum)是臭名昭著的有毒黑霉。它通常表现为黑色或绿黑色,可以生长在漏水的地方、旧的腐烂的木材、纸张和食物中。S. chartarum需要持续的水分来维持生长,所以这些地方解决得越快,它的威胁就越小。你可能会发现黑霉菌在洪水过后出现在房子里,或屋顶漏水的地方。S. chartarum如此危险的原因是,它产生一种叫做霉菌毒素(mycotoxin)的真菌副产品,可以喷射到空气中,被人类和动物吸入。研究表明,在美国,暴露于像S. chartarum这样的室内有毒霉菌所造成的死亡人数远远超过以前的想象。暴露于像S. chartarum所产生的霉菌毒素,会导致头痛、打喷嚏、咳嗽、皮疹,有时甚至是血液中毒。
链格孢(Alternaria)属
意识到黑色的霉菌可能是S. chartarum是至关重要的,但也有很大可能是链格孢曲霉菌,它的危险性要小得多。链格孢属的霉菌通常生长在室外多尘、潮湿的地方,靠近植物和土壤;不过,最近它们被发现可能生长在房屋里。接触Alternaria可能会加剧哮喘,但除此之外,它并不构成很多健康风险。
曲霉(Aspergillus)属
曲霉菌是另一种常见的真菌,研究表明你实际上每天通过呼吸吸入大量曲霉菌。大量接触可能会导致曲霉病以及其他呼吸系统问题。
枝孢菌(Cladosporium)属
家中的黑色霉菌也可能是枝孢霉菌的一种,它通常生长在室外的腐烂树叶上。它也可以在室内找到,并在墙壁、绝缘材料和地毯上定居,接触它有时会导致皮疹、眼睛刺激和窦感染。
紫色霉菌
紫色不是一种常见的霉菌颜色,但如果你看到它,它可能是有毒的纸葡萄穗菌(Stachybotrys chartarum)的变体。
白色霉菌
白色是生长在家中的霉菌的另一种常见颜色,它可能是几种不同的类型之一。
链格孢(Alternaria)属
在你的家里发现的任何白色霉菌很有可能是链格孢菌。这也说明,一种霉菌可以根据条件而改变颜色。
毛壳菌(Chaetomium)属
毛壳菌是一种可以在任何地方生长的霉菌,它的适应性和复原力很强。它可以在许多宿主身上生长,不管它们是什么做的,但它更喜欢潮湿、黑暗的地方。有些人可能会把它描述成像棉花一样的外观,而其他人可能会把它写成地下室墙壁上的盐渍。毛壳菌的一个显著特征是它的气味;它通常是你在地下室、阁楼和食物上可能闻到的霉味的罪魁祸首。
青霉(Penicillium)属
青霉菌是另一种多色真菌,有时可以是白色。青霉菌属的发现是医学领域的一个重要步骤,因为它导致了青霉素的诞生。它可以在高湿度的食物和墙壁上发现,虽然它是青霉素的重要成分,但如果处理不当,会引起严重的过敏反应。
蓝色霉菌
蓝色是在食物和墙壁上发现的青霉菌的另一种常见颜色。
粉红色霉菌
如果你的浴帘或浴缸有一段时间没有清洗,你可能会发现它们有一层变色的粉红色薄膜,这就是所谓的“粉红色霉菌”。不过,称其为霉菌是一种误解,因为它实际上是一种叫做粘质沙雷氏菌(Serratia marcescens)的细菌,在肥皂残留物上生长。除了经常地清洁你的浴室外,没有永久地解决办法,但尽管它可能导致尿路感染和呼吸道问题,幸运的是它不容易被感染。
黄色霉菌
黄色是一个需要注意的颜色,因为其中一些霉菌如果不加控制可能会有危险。
曲霉(Aspergillus)属
有时曲霉菌会出现黄色。正如之前在黑霉菌部分提到的,这是一种在房屋中非常常见的霉菌类型,基本上是低风险的。
干朽菌(Serpula lacrymans)
干朽菌对人类来说并不危险,但它对木质结构的完整性有很大的影响。这种真菌是潮湿和腐烂的有机材料的优秀破坏者,如果不清除,会给你的房子带来灾难。它生长迅速,如果条件理想,可以轻松地吞噬室内和室外的木质表面。
黑附球菌(Epicoccum nigrum)
黑附球菌是一种快速生长的黄色霉菌,可以在潮湿的干墙、床垫、木材、地毯和家具上发现。它的颜色从黄色到橙色到棕色不等,取决于条件和周围环境。
毡状金孢霉菌(Geomyces pannorum)
毡状金孢霉菌是一种比本列表中的其他真菌更独特的真菌:--它只在较冷的条件下生长。这意味着在北半球的气候条件下,它基本上只能在潮湿的墙壁、地板、木材和纸张上生长。
黄色粘液霉菌(Yellow Slime Mold)
如果你在家里遇到一种粘稠的亮黄色霉菌,请离它非常远。尽量不要触摸它或吸入它。亮黄色的霉菌通常不是真正的霉菌,而是一种无关的生物,称为“粘液霉菌”。粘液霉菌可能有很强的毒性,不应轻易接触。本清单中的其他黄色霉菌都不是亮黄色的,它们更像是白色或棕黄色的,所以黄色粘液霉菌应该很容易区分。
红色霉菌
你可能会在建筑材料上发现红色霉菌,如受到水损害的刨花板或干墙。红色通常不是霉菌的一贯颜色,它通常会随着时间的推移而改变颜色。许多种类的霉菌在其生命中的某个阶段都会变成红色,但由于其普遍性,最可能是曲霉菌。然而,如果你在食物上发现红色霉菌,那可能是神经孢子菌。
橙色霉菌
橙色霉菌与干朽菌(Serpula lacrymans)相似,它是一种快速生长的霉菌,随着时间的推移会对木质结构造成严重损害。它经常出现在家庭内部或外部的木质表面,如桌子、椅子、横梁和地板。接触橙色霉菌可能会加重哮喘和其他呼吸道疾病,但它通常几乎不构成健康风险。
棕色霉菌
棕色是另一种颜色,可能存在于几个不同的霉菌群中。许多棕色的霉菌可以在较硬的表面迅速传播,虽然它们可能会引起一些人的过敏,但它们在很大程度上是比较安全的。许多这类霉菌都有一种非常臭的气味。棕色霉菌可以是以下任何一种类型:纸样皮氏霉菌(Pithomyces chartarum)、黑酵母菌(Aureobasidium pullulans)、发网菌(Stemonitis)属、枝孢菌(Cladosporium)属和毛霉菌(Mucor)属
当涉及到棕色霉菌通常是安全的时候,毛霉菌是一个例外。毛霉菌是一种在周围非常危险的霉菌类型,有时会引起危及生命的血液感染,称为毛霉菌病(mucormycosis)。这是一种难以区分的霉菌,因为在其生命周期的任何时候,它都可能是棕色、黄色、黑色、白色或灰色。